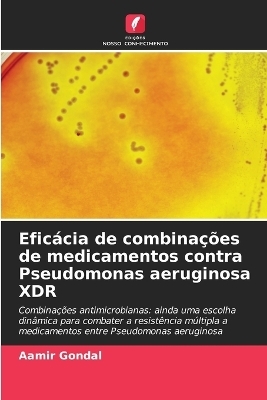
Eficácia de combinações de medicamentos contra Pseudomonas aeruginosa XDR

Buch | Softcover
2025
|
Editions Notre Savoir
ISBN: 9786200724540
CHF 149,95 (inkl. MwSt)
- Titel nicht im Sortiment